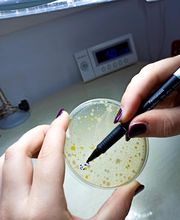
Gallery Cliente
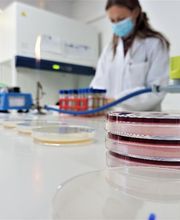
Gallery Cliente

Mineral SRL
Artigianato · Atelier · Vendita al dettaglio
Via Aldo Moro 20, 41043 FormigineRicerca
+390598725225 (Telefono)
+393463245029 (Mobil)
Dal 2012 affianchiamo le aziende con una vasta gamma di servizi: Laboratorio Analisi per aziende Alimentari, Acque potabili, Piscine, Pozzi Analisi Legionella Consulenza HACCP, notifiche sanitarie, Etichettatura, Allergeni Formazione HACCP Alimentarista Formazione Sicurezza Formazione Legionella La continua formazione interna e la passione per questo lavoro, sono il motore che permette a tutto lo staff di assecondare ogni richiesta con attenzione e competenza. Ulteriore punto di forza è la piccola dimensione permette sempre il contatto diretto con il responsabile dell'attività.

Via Aldo Moro, 20, 41043 Formigine
Artigianato · Atelier · Vendita al dettaglio
Via Aldo Moro 20, 41043 FormigineForniture industriali · Veicoli commerciali
Via Aldo Moro 35, 41043 Formigine